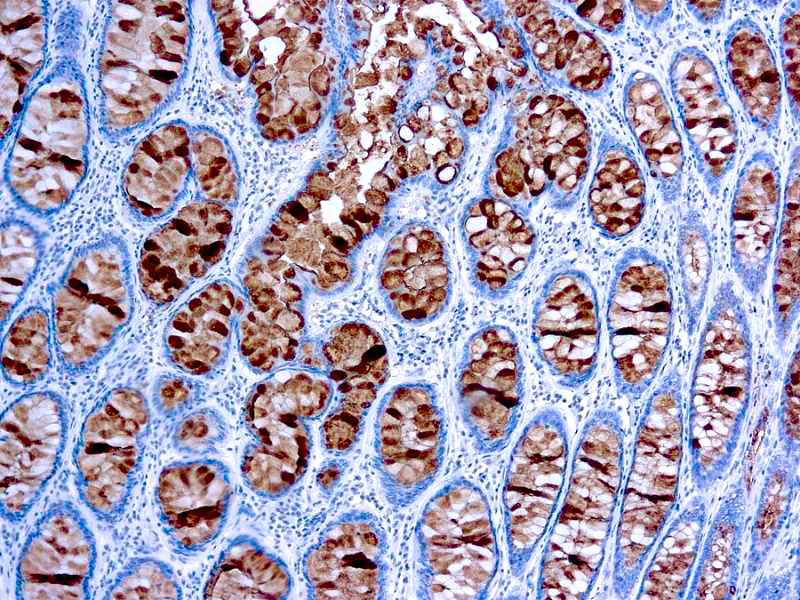
CA 19-9

1
/
of
1
Dbiosys
SKU:Mob109
CA 19-9
CA 19-9
Regular price
$445.00 USD
Regular price
Sale price
$445.00 USD
Unit price
/
per
Shipping calculated at checkout.
Couldn't load pickup availability
This antibody reacts specifically with sialyl Lewisa and recognizes an epitope being designated CA 19-9. It does not cross-reacts with Lewisa and Lewisb. CA 19-9 has been shown to be useful marker in the diagnosis and management of gastrointestinal cancers.
Share